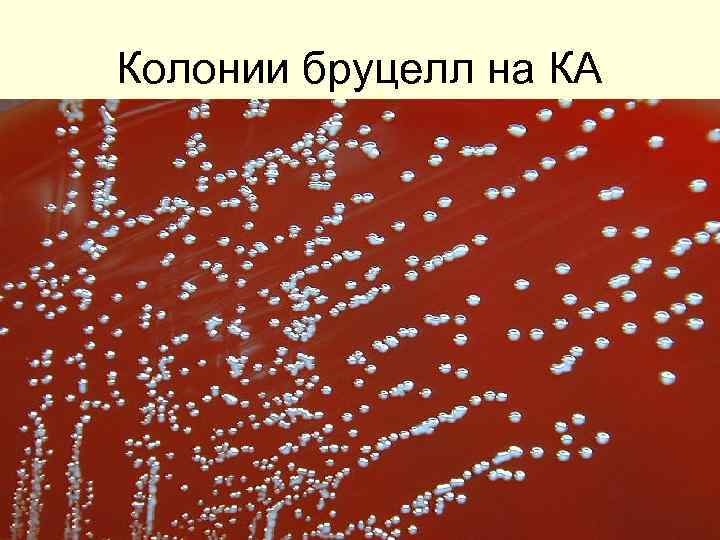
Колонии бруцелл на КА
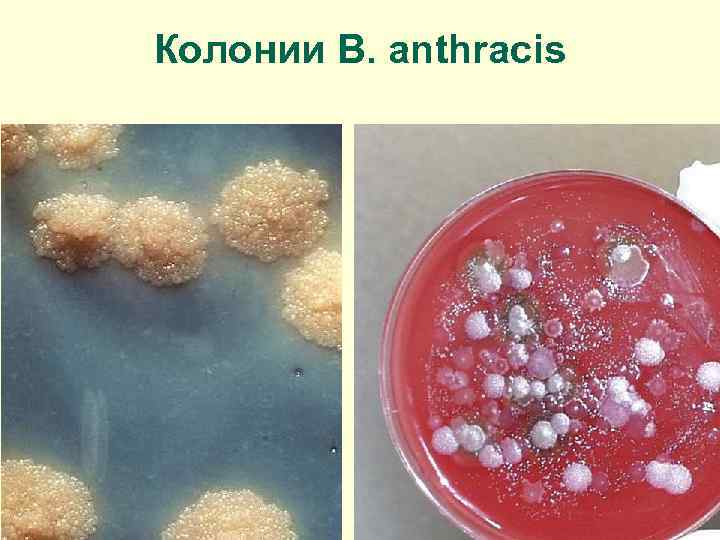
Колонии B. anthracis

Зан 1 Бруцеллёз и СЯ.ppt
- Количество слайдов: 42

Лабораторная диагностика бруцеллёза

Бруцеллёз — зоонозная инфекция

Род Brucella - 10 видов B. melitensis (3 биовара; преимущественно поражает коз и овец, возможна миграция на крупный рогатый скот и свиней), B. abortus (7 биоваров; вызывает аборты и орхиты у крупного рогатого скота), B. suis (5 биоваров; поражает свиней, зайцев, северных оленей, грызунов), B. neotomae (выделяется от пустынной кустарниковой крысы), B. ovis (вызывает эпидидимиты и орхиты у баранов), B. canis (поражает собак). Вновь зарегистрированные бруцеллы: B. ceti выделяются от китообразных, B. pinnipedialis - от ластоногих B. microti - от серой полевки, B. inopinata - источник не установлен. Заболевания людей преимущественно вызывают B. melitensis, B. abortus и B. suis биовары 1 - 4, реже - B. canis

Бруцеллы в мазке из чистой культуры Бруцеллы в мазке-отпечатке из тканей Окраска по методу Грама
Колонии бруцелл на КА

Бруцеллы обитают в организме млекопитащих преимущественно внутри макрофагов и плацентарных трофобластов.

ЭПИДЕМИОЛОГИЯ БРУЦЕЛЛЕЗА

КЛИНИЧЕСКИЕ ПРОЯВЛЕНИЯ БРУЦЕЛЛЕЗА ГЛАЗА Кератит Язва роговицы Увеит Эндофтальмит ОРГАНЫ ДЫХАНИЯ Бронхит Бронхопневмония Лимфоаденопатия корня легкого Абсцесс легкого Плеврит ЖКТ Гепатит Илеит Панкреатит Холецистит Перитонит КОЖНЫЕ ПОКРОВЫ Узелковая эритема Васкулит ЦНС Менингит Энцефалит Психоз Полирадикулит Периферическая нейропатия ССС Эндокардит Миокардит Перикардит МПС Орхит Гломерулонефрит Интерстициальный нефрит Пиелонефрит Аборт ОДС Артрит (сакроилеит) Остеомиелит

Лабораторная диагностика бруцеллёза Клинический материал: кровь, костный мозг, спинномозговая жидкость, пунктат из лимфоузлов, моча, желчь, суставная жидкость (при артритах), гной (при абсцессах). Материал из объектов внешней среды, продукты.

БАКТЕРИОЛОГИЧЕСКИЙ МЕТОД пересев клинического материала с транспортной среды на плотные и жидкие среды; инкубация при 37 °С до 20 - 30 сут. ; 3 - 21 сут. от начала исследования: - учет результатов роста, бактериоскопия; - постановка реакции агглютинации (МФА) отобранных изолированных колоний с сывороткой бруцеллезной диагностической поливалентной для РА; - отсев для получения чистой культуры; 5 - 30 дней от начала исследования: постановка с культурами возбудителя бруцеллеза, находящимися в стабильной S-форме, тестов межвидовой дифференциации: - отношение к избыточному содержанию углекислоты в воздухе; - образование сероводорода; - редукция красителей (тионин, основной фуксин); - агглютинация моноспецифическими бруцеллезными сыворотками (anti-abortus, anti-melitensis); - чувствительность к бруцеллезному бактериофагу Тб; - чувствительность к антибактериальным препаратам диско-диффузионным методом; 10 - 40 сут. от начала исследования: учет результатов.

БИОЛОГИЧЕСКИЙ МЕТОД - заражение биопробных животных (морские свинки, белые мыши) подкожно в паховую область или внутрибрюшинно - при исследовании крови, спинномозговой жидкости, костного мозга. 20 -35 сут. от начала исследования: - вскрытие биопробных животных, посев на питательные среды патологического материала: лимфатические узлы (регионарные в месте введения исследуемого материала, паховый, подчелюстной, шейный, парааортальный), кусочки органов (селезенка, печень, костный мозг), кровь; - приготовление мазков-отпечатков из органов биопробных животных, постановка МФА; - постановка ПЦР (суспензия из гомогената органов, лимфатических узлов, костный мозг, сыворотка крови); - постановка реакций агглютинации 40 сут. от начала исследования: учет результатов.

Забор крови Отстаивание 1 -2 часа 20 С СЕРОЛОГИЧЕСКИЙ МЕТОД (реакции агглютинации Хеддельсона и Райта, реакция Кумбса, РНГА, ИФА )

Протокол. Лабораторная диагностика бруцеллеза Исследуемый материал Мазок из чистой культуры бруцелл, окраска по Граму Что сделать Изучить морфологию (демонстрация), зарисовать Сыворотка крови Поставить и учесть больного реакцию Хеддльсона, дать заключение, зарисовать Сыворотка крови больного Поставить и учесть реакцию Райта, дать заключение Результат Рисунок, заключение Заключение

Схема реакции Хеддельсона Опыт 0, 08 мл исследуемой сыворотки и 0, 03 мл диагностикума Хеддльсона 0, 02 мл исследуемой сыворотки и 0, 03 мл диагностикума Хеддльсона 0, 04 мл исследуемой сыворотки и 0, 03 мл диагностикума Хеддльсона 0, 01 мл исследуемой сыворотки и 0, 03 мл диагностикума Хеддльсона Контроль антигена 0, 03 мл физиологического раствора и 0, 03 мл диагностикума Хеддльсона

СХЕМА ПОСТАНОВКИ РЕАКЦИИ РАЙТА

№№ пробирок Ингредиенты Сыворотка больного (разведение 1: 100) Физиологический раствор Разведения сыворотки Контроли 1 2 3 4 5 6 1: 100 КА 1: 200 1: 400 1: 800 КС 1 мл 1 мл - - 1 мл - 0, 1 мл (2 к. ) Диагностикум 0, 1 мл бруцеллезный (2 к. ) 0, 1 мл (2 к. ) 37˚ С - 2 часа 0, 1 мл (2 к. ) 1 мл вылить

Учет результатов Диагностический титр - 1: 200 1: 100 1: 200 1: 400 1: 800

Аллергический метод Проба Бюрне с бруцеллином Brucellinum Бруцеллин — фильтрат 30 -дневной бульонной культуры трех типов бруцелл Показания к применению Бруцеллин применяется для диагностики бруцеллеза у людей и выявления иммунологической перестройки организма после вакцинации. Правила применения Бруцеллин вводят внутрикожно в дозе 0, 1 мл в ладонную поверхность предплечья. Оценка результата 24 -48 часов Размер гиперемированного и отечного участка: - до 1 см – peaкция сомнительная; - 1 -3 см – реакция слабо положительная; - 3 -6 см – реакция положительная; - более 6 см – реакция резко положительная.

Молекулярно-генетические методы исследования ПЦР ü с пробами из нативного материала ü с материалом из подозрительных колоний; ü с материалом от биопробных животных ü с пробами из объектов внешней среды, продуктов

Специфическая профилактика

Вакцина для профилактики бруцеллеза Культура живых микробов вакцинного штамма Вrucella abortus 19 ВА. Через 20 -30 дней после вакцинации развитие иммунитета до 10 -12 мес, максимальная напряженность сохраняется 5 -6 мес. Вакцинацию следует проводить не позднее, чем за 3 -4 нед до начала работы, связанной с риском заражения.

Вакцина бруцеллезная инактивированная лечебная Лекарственная форма: лиофилизат для приготовления раствора для подкожного введения и накожного нанесения, суспензия для инъекций

Лабораторная диагностика сибирской язвы

Сибирская язва — особо опасная инфекция (ООИ)

Классификация Семейство Bacillaceae Род Bacillus Вид B. anthracis

B. аnthracis мазок из стареющей культуры (окраска по Граму)) мазок-отпечаток из пораженных тканей
Колонии B. anthracis


Кожная форма сибирской язвы

Лабораторная диагностика сибирской язвы материал для исследования а) от больных или подозрительных на заболевание людей в зависимости от формы заболевания содержимое везикул, отделяемое карбункула или язвы, струпья, мокрота, кровь, спинномозговая жидкость, моча, испражнения, экссудаты; б) трупный материал - кровь, экссудаты, кусочки органов (селезенки, печени, лимфоузлов и др. ); в) материал от животных; г) продовольственное сырье и продукты животного происхождения; д) объекты окружающей среды - почва, трава, фураж, подстилка, вода и т. д.

БАКТЕРИОСКОПИЧЕСКИЙ МЕТОД СВЕТОВАЯ МИКРОСКОПИЯ

ЛЮМИНИСЦЕНТНАЯ МИКРОСКОПИЯ (МФА)

БАКТЕРИОЛОГИЧЕСКИЙ МЕТОД I уровень исследования Посевы материала на: МПА, агар. Хоттингера , агар с фенолфталеинфосфатом (на щелочную фосфатазу) МПБ. Инкубация (36 +/- 1) °С на 18 - 20 ч (до 48 ч) Через 24 часа Оценка характера роста Бактериоскопия Оценка активности щелочной фосфатазы (нет розовых колоний при обработке аммиаком) МФА и ПЦР с материалом из типичных колоний Высев для накопления чистой культуры

I I уровень исследования идентификация Оценка характера роста чистой культуры Бактериоскопия Определение подвижности (рост на полужидком агаре по следу укола) Капсулообразование (слизистый рост на сывороточных средах, бактериоскопия) Чувствительность к бактериофагам Гемолиз эритроцитов барана (рост на кровяном агаре) Чувствительность к пенициллину ( «жемчужное ожерелье» , диско-диффузионный метод)

I I I уровень исследования Дополнительные тесты Чувствительность к антибиотикам Протеолитические свойства: Желатин Казеин Альбумин Гемоглобин Лецитиназная активность Рост на минимальной среде Оценка вирулентности на среде с противосибиреязвенным иммуноглобулином (слизистые колонии, капсула в мазке, преципитация вокруг колоний)

Биологический метод Животные - белые беспородные мыши, морские свинки, золотистые хомячки. Инфицирование - внутренняя поверхность бедра Гибель - чаще через 1 - 3 сут. Студенистый геморрагический отек подкожной клетчатки на месте введения материала, гиперемия внутренних органов, увеличение селезенки, несвернувшаяся кровь. Из тканей и органов - мазки-отпечатки, посевы.

Молекулярно-генетические методы исследования ПЦР ü ü с пробами из нативного материала с материалом из подозрительных колоний; с материалом от биопробных животных с пробами из объектов внешней среды, продуктов

Выявление сибиреязвенного антигена МФА, р Асколи Реакция термокольцепреципитации Асколи

Серологический метод МФА (непрямой), РНГА Специфические антитела с 5 -х сут. после начала болезни, титр нарастает до 21 и более суток. Увеличение титра в парных сывороток с интервалом 5 - 7 дней. В МФА: диагностические титры 1: 16 - 1: 32 или 4 -кратное нарастание при повторном исследовании.

Аллергический метод Антраксин (anthraxinum) - гидролизат вегетативных форм сибиреязвенных бацилл. Вводят 0, 1 мл строго внутрикожно. Результат положительный: через 24 - 48 ч участок гиперемии с инфильтрацией не менее 16 -25 мм в диаметре. Реакция сомнительная - до 15 мм, требует повторения через 5 -7 дней.

Протокол. Лабораторная диагностика сибирской язвы Исследуемый материал Что сделать Мазок-препарат из отделяемого Изучить, зарисовать сибиреязвенног о карбункула Результат Рисунок Выращенные посевы отделяемого сибиреязвенног о карбункула Изучить морфологию колоний. Описание колоний Приготовить мазок из колоний, окрасить по Граму, зарисовать Рисунок Экстракт из шерсти животного Поставить реакцию Асколи, дать заключение, зарисовать Рисунок, заключение

Вакцина сибиреязвенная живая сухая для подкожного и скарификационного применения Вакцина - живые споры вакцинного сибиреязвенного штамма СТИ, лиофилизированные. Схема вакцинации: двукратная 0 день – 20 день или 30 день. Ревакцинация ежегоднократно.
Зан 1 Бруцеллёз и СЯ.ppt